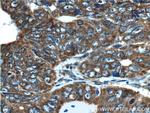
TCP1 Antibody in Immunohistochemistry (Paraffin) (IHC (P))
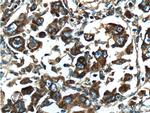
TCP1 Antibody in Immunohistochemistry (Paraffin) (IHC (P))

Search
Proteintech
TCP1 Polyclonal Antibody
{{$productOrderCtrl.translations['antibody.pdp.commerceCard.promotion.promotions']}}
{{$productOrderCtrl.translations['antibody.pdp.commerceCard.promotion.viewpromo']}}
{{$productOrderCtrl.translations['antibody.pdp.commerceCard.promotion.promocode']}}: {{promo.promoCode}} {{promo.promoTitle}} {{promo.promoDescription}}. {{$productOrderCtrl.translations['antibody.pdp.commerceCard.promotion.learnmore']}}
产品信息
10320-1-AP
种属反应
已发表种属
宿主/亚型
分类
类型
抗原
偶联物
形式
浓度
规格
纯化类型
保存液
内含物
保存条件
运输条件
产品详细信息
Immunogen sequence: QKILATGAN VILTTGGIDD MCLKYFVEAG AMAVRRVLKR DLKRIAKASG ATILSTLANL EGEETFEAAM LGQAEEVVQE RICDDELILI KNTKARTSAS IILRGANDFM CDEMERSLHD ALCVVKRVLE SKSVVPGGGA VEAALSIYLE NYATSMGSRE QLAIAEFARS LLVIPNTLAV NAAQDSTDLV AKLRAFHNEA QVNPERKNLK WIGLDLSNGK PRDNKQAGVF EPTIVKVKSL KFATEAAITI LRIDDLIKLH PESKDDKHGS YEDAVHSGA (276-553 aa encoded by BC000665)
靶标信息
The T Complex Polypeptide 1 (TCP-1) is approximately 60 kDa protein constitutively expressed in almost all eukaryotic cells, and is upregulated during spermatogenesis. It is found in the cytosol as a subunit of a hetero-oligomeric chaperone that is known to be involved in the folding of actin and tubulin. The family of proteins termed chaperonins act to recognize and stabilize polypeptide intermediates during folding, assembly and disassembly, and share many characteristics with Heat Shock Protein 70 (HSP70) including high abundance, induction by environmental stress, and ATPase activity. The chaperonin family includes the mitochondrial HSP60, Escherichia coli GroEL, the plastid Rubisco-subunit binding protein, and the archaebacterial protein TF55. The TCP-1 sequence shows nearly 40% identity to TF55, but only minimal similarity to HSP60 and GroEL.
仅用于科研。不用于诊断过程。未经明确授权不得转售。
生物信息学
蛋白别名: CCT-alpha; Chaperonin containing T-complex polypeptide 1 subunit 1; t-complex 1 protein; t-complex polypeptide 1; T-complex protein 1 subunit alpha; T-complex protein 1 subunit alpha A; T-complex protein 1 subunit alpha B; T-complex protein 1, alpha subunit; tailless complex polypeptide 1; Tailless complex polypeptide 1A; Tailless complex polypeptide 1B; TCP-1-A; TCP-1-alpha; TCP-1-B
基因别名: AI528772; c-cpn; CCT; CCT-alpha; CCT1; CCTA; D6S230E; IDDPMGS; p63; Tcp-1; TCP-1-alpha; TCP1; Tp63; TRic
UniProt ID: (Human) P17987, (Mouse) P11983
Entrez Gene ID: (Human) 6950, (Mouse) 21454